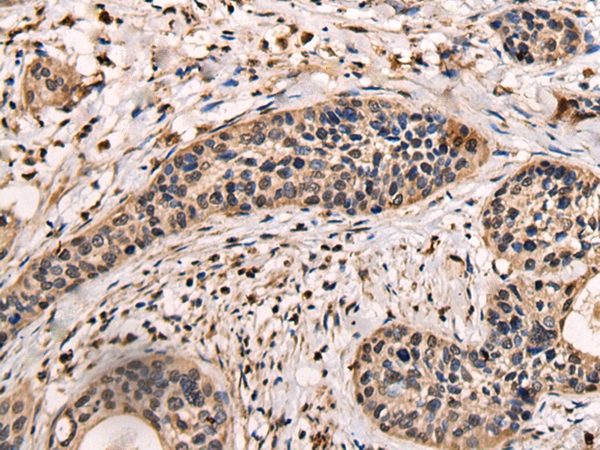

中文名稱:兔抗ASXL2多克隆抗體
|
Background: |
ASXL2 is a human homolog of the Drosophila asx gene. Drosophila asx is an enhancer of trithorax (see MIM 159555) and polycomb (see MIM 610231) (ETP) gene that encodes a chromatin protein with dual functions in transcriptional activation and silencing (Katoh and Katoh, 2003 [PubMed 12888926]). |
|
Applications: |
ELISA, IHC |
|
Name of antibody: |
ASXL2 |
|
Immunogen: |
Fusion protein of human ASXL2 |
|
Full name: |
additional sex combs like 2, transcriptional regulator |
|
Synonyms: |
ASXH2 |
|
SwissProt: |
Q76L83 |
|
ELISA Recommended dilution: |
5000-10000 |
|
IHC positive control: |
Human cervical cancer |
|
IHC Recommend dilution: |
25-100 |
購物車
購物車 幫助
幫助
 021-54845833/15800441009
021-54845833/15800441009
